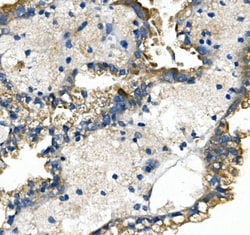
Invitrogen GLUT9 Polyclonal Antibody 100 &mu;g; Unconjugated:Antibodies,

Learn More
Invitrogen™ GLUT9 Polyclonal Antibody


Rabbit Polyclonal Antibody
Brand: Invitrogen™ PA5143879
Description
Adding 0.2 mL of distilled water will yield a concentration of 500 μg/mL. Positive Control - WB: human HepG2 whole cell, human HEK293 whole cell, human HEK293 whole cell, human A549 whole cell, human A431 whole cell, human Hela whole cell, rat kidney tissue, rat liver tissue, mouse RAW2647 whole cell. IHC: human prostatic cancer tissue, human renal cancer tissue, mouse kidney tissue, rat kidney tissue. ICC/IF: A549 cell. Flow: U937 cell. Store at -20°C for one year from date of receipt. After reconstitution, at 4°C for one month. It can also be aliquotted and stored frozen at -20°C for six months. Avoid repeated freeze-thaw cycles.
GLUT9, or SLC2A9, is a member of the SLC2A facilitative glucose transporter family. Members of this family play a significant role in maintaining glucose homeostasis. GLUT9 may play a role in the development and survival of chondrocytes in cartilage matrices. Two transcript variants encoding distinct isoforms have been identified for this gene.
Specifications
| GLUT9 | |
| Polyclonal | |
| Unconjugated | |
| SLC2A9 | |
| facilitated glucose transporter, type 9; glucose transporter type 9; GLUT9; GLUT-9; GLUTX; human glucose transporter-like protein-9; Slc2a9; SLC2a9A; SLC2A9B; solute carrier family 2 (facilitated glucose transporter), member 9; solute carrier family 2 member 9; solute carrier family 2, facilitated glucose transporter member 9; UAQTL2; Urate transporter; urate voltage-driven efflux transporter 1; URATv1 | |
| Rabbit | |
| Antigen affinity chromatography | |
| RUO | |
| 56606 | |
| -20°C | |
| Lyophilized |
| ELISA, Flow Cytometry, Immunohistochemistry (Paraffin), Western Blot, Immunocytochemistry | |
| 500 μg/mL | |
| PBS with 4mg trehalose and 0.05mg sodium azide | |
| Q9NRM0 | |
| SLC2A9 | |
| E.coli-derived human GLUT9/SLC2A9 recombinant protein (Position: R7-P540). | |
| 100 μg | |
| Primary | |
| Human | |
| Antibody | |
| IgG |
Your input is important to us. Please complete this form to provide feedback related to the content on this product.